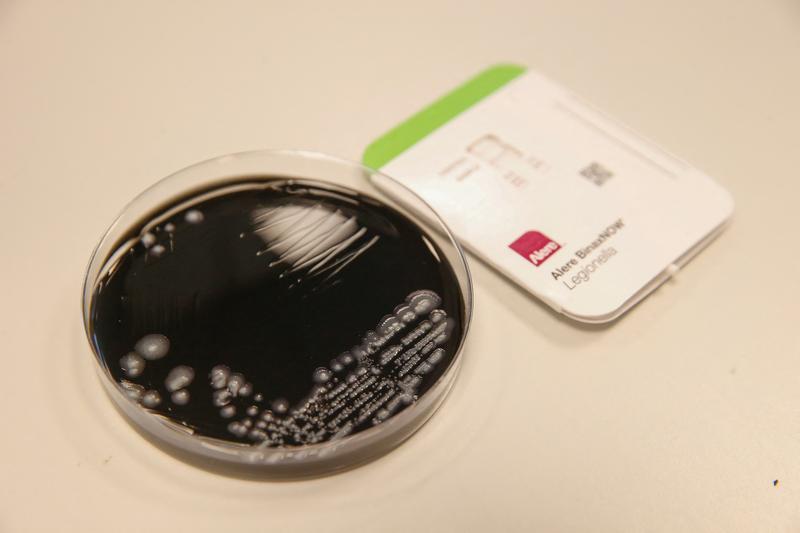
test antigen pentru detectarea bacteriei legionella, Foto: NICOLAS MAETERLINCK / AFP / Profimedia

Boala legionarului ucide trei persoane într-un oraș din Polonia / Alte 71 de persoane sunt internate în spital
Trei persoane au murit din cauza legionelozei, boala cauzată de bacteria legionella, în orașul Rzeszow din sud-estul Poloniei, iar alte 71 au fost internate în spital, a declarat miercuri un purtător de cuvânt al spitalului local pentru AFP.
„Trei persoane au murit de legioneloză, a spus Andrzej Sroka de la spitalul universitar, sunt persoane în vârstă”.
Serviciile locale de sănătate au indicat într-un comunicat de presă că în total 71 de persoane au fost internate în urma contaminării cu această bacterie, provocând grave probleme respiratorii.
Celulă de criză în Rzeszow din cauza bolii legionarului
Sursa contaminării nu este cunoscută, iar municipalitatea Rzeszow a convocat o celulă de criză.
Dezinfectarea suplimentară a rețelei de alimentare cu apă din oraș este planificată în weekend.
Rezultatele examinărilor probelor de apă prelevate din diferite izvoare vor fi cunoscute luni.
Boala legionarului este o infecție pulmonară gravă de origine bacteriană, iar infectarea se poate face pe cale respiratorie prin inhalarea bacteriilor, prin apă sau aer condiționat.






